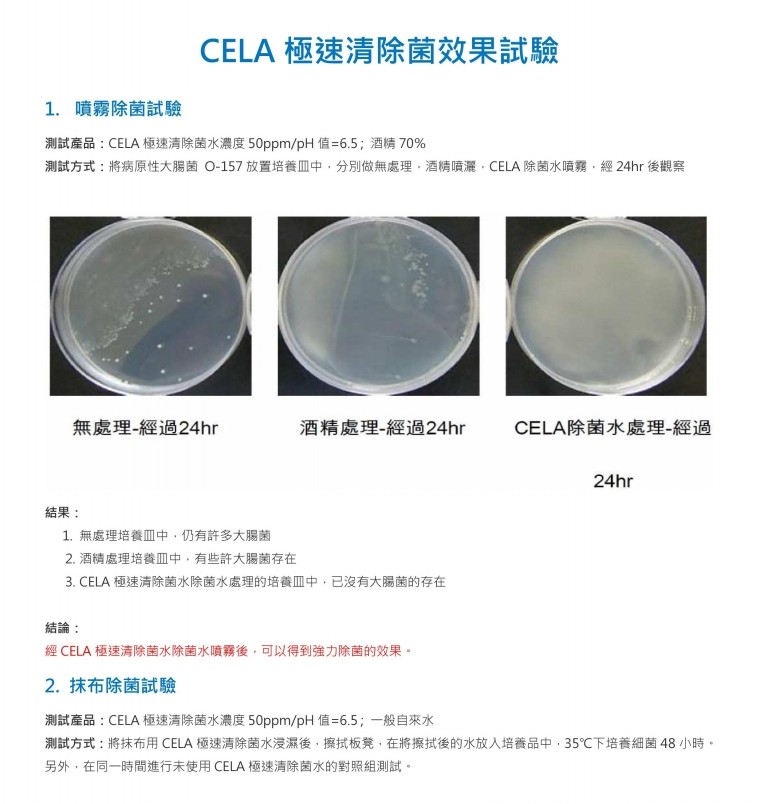

お買い物かごに商品がございません
カートに追加する ×
◎ 使用方法:
1. 先將透明的蓋子取出,按壓噴頭數次,直到霧氣出來為止。
2. 對想除菌除臭的地方,以 20~30 公分距離直接噴霧。
3. 請不要以橫向或是逆向方式噴霧。
◎ 注意事項:
1. 請放置於幼兒接觸不到以及陽光不會直接照射的地方。
2. 請於開封後六個月內使用。
3. 請勿飲用。
◎ 商品規格:
日本CELA(セラ) 極速清 次氯酸除菌水(300ml)
產品名稱:CELA-300ml
產品容量:300 毫升
產品成分:弱酸性次氯酸
保存期限:18 個月
使用期限:請於開封後 6 個月內使用